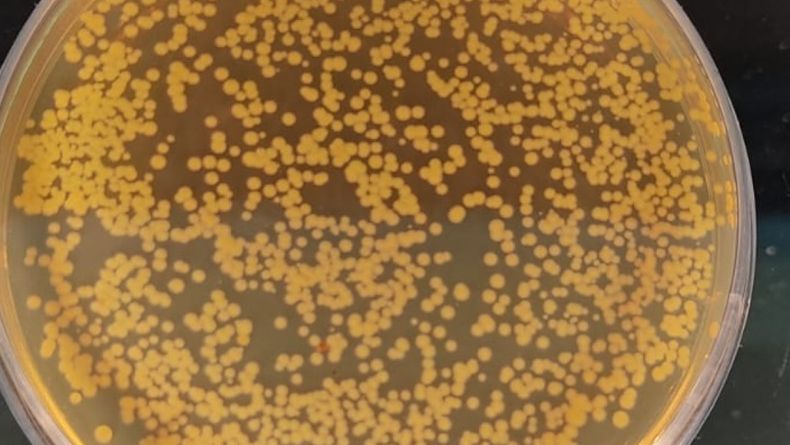
“La resistencia antimicrobianaes un problema que lejos de solucionarse nos plantea un desafío constante”

Bajo el lema "Educar. Promover. Actuar ahora" se realiza una nueva edición de la Semana de la Concientización sobre la Resistencia Antimicrobiana (RAM). Desde el Instituto de Patobiología del Centro de Investigación en Ciencias Veterinarias y Agronómicas (CICVyA) del INTA avanzan en el desarrollo de alternativas y estrategias para evitar el uso innecesario de antimicrobianos en la producción animal.
La resistencia a los antimicrobianos (RAM) representa una crisis mundial urgente, con gran impacto en salud humana y animal. Además del impacto sanitario esta problemática posee graves consecuencias socioeconómicas que afectan principalmente a los sectores más vulnerables de la población comprometiendo los objetivos de desarrollo sustentable propuestos por Naciones Unidas para generar conciencia acerca de la gravedad de este fenómeno.
Con el fin de generar conciencia sobre la problemática y promover el uso responsable de antimicrobianos, en el año 2015 se propone la semana de concientización sobre la RAM, la cual es impulsada por las organizaciones mundiales de Sanidad Animal (OMSA), y de la Salud (OMS), y de las Naciones Unidas para la Alimentación y la Agricultura (FAO). Este año, además, se suma el Programa de las Naciones Unidas para el Medio Ambiente (UNEP).
Actividades de concientización
Dentro de las actividades vinculadas al control de la RAM, en esta oportunidad se destaca el rol de la educación de la población general bajo el lema "Educar. Promover. Actuar ahora", resaltando la necesidad de toma de compromisos audaces, y que los sectores relevantes sobre la RAM adopten medidas concretas en respuesta a esta problemática.
La resistencia a los antimicrobianos es un problema que lejos de solucionarse nos plantea un desafío constante con el que tendremos que aprender a convivir La resistencia a los antimicrobianos es un problema que lejos de solucionarse nos plantea un desafío constante con el que tendremos que aprender a convivir
“Aunque desde hace años se vienen desarrollando diversas actividades vinculadas al monitoreo de RAM en humanos, animales y medio ambiente desde la perspectiva de Una Salud, todavía queda mucho por hacer en cuanto a la sensibilización de actores relevantes y la población en general”, indicó Leandro Redondo, investigador del Instituto de Patobiología del Centro de Investigación en Ciencias Veterinarias y Agronómicas (CICVyA) del INTA.
En este sentido, -explicó Redondo- en el año en curso se han realizado reuniones de alto nivel donde se destacó la necesidad de mayor liderazgo político que permita definir metas acordadas a nivel mundial y una mayor responsabilidad en las acciones contra la RAM (Reunión de Alto Nivel sobre la RAM de la Asamblea General de las Naciones Unidas (AGNU) 2024 y la 4ta Conferencia Ministerial Mundial de Alto Nivel sobre la RAM).
>> Leé más: OMSA advierte sobre las graves consecuencias de la resistencia antimicrobiana
El trabajo del INTA
De acuerdo con el investigador, “en línea con estos llamados a la acción, el INTA lleva adelante actividades de monitoreo de la RAM en diferentes sistemas productivos de nuestro país, promoviendo el uso responsable de antimicrobianos y favoreciendo su reemplazo por productos alternativos”.
Redondo especificó que el organismo desarrolla diferentes productos alternativos a los antimicrobianos que permitan controlar las enfermedades infecciosas y aumentar la eficiencia productiva, reduciendo la necesidad del uso de antimicrobianos. Además, elabora estrategias que permitan reducir la necesidad de antimicrobianos, ya sea mediante el uso eficiente de productos alternativos o la adaptación de medidas de bioseguridad o manejo de residuos.
RAM 2.jpeg
El INTA lleva adelante actividades de monitoreo de la RAM en diferentes sistemas productivos del país.
INTA
“Llevamos adelante líneas de investigación para determinar el impacto ambiental, económico y social de la RAM en producción animal”, afirmó Redondo. Estas actividades se realizan dentro del programa nacional de Salud Animal, y se articula con diversas iniciativas de proyectos de investigación liderado por técnicos de la institución en colaboración con organismos nacionales e internacionales, del sector público y/o privado.
“Estas colaboraciones tienen como objetivo final generar intervenciones que puedan sostenerse a largo plazo, permitiendo reducir el uso de antimicrobianos en producción animal sin comprometer la eficiencia productiva y la inocuidad de los productos derivados, reduciendo el impacto ambiental de esas producciones aumentando la sostenibilidad de los sistemas productivos”, especificó el especialista. Y agregó: “Esto también permite la diferenciación de productos promoviendo emprendimientos locales”.
Últimos avances
Recientemente, la Comisión Nacional de Control de la Resistencia Antimicrobiana celebró su Reunión Anual Ordinaria contando con la participación de representantes de la cartera nacional de Salud, de la subsecretaría de Ambiente, referentes jurisdiccionales, organismos descentralizados (CONICET, INTA, SENASA, ANMAT y ANLIS “Carlos G. Malbrán”); sociedades científicas y organismos de salud internacionales.
En esta oportunidad se destaca el rol de la educación de la población general bajo el lema «Educar. Promover. Actuar ahora»
En esta reunión se presentaron los últimos avances en registro de consumo de antimicrobianos en hospitales, avances en la implementación de la Ley 27.680, novedades en la vigilancia de eventos de pandrogoresistencia y se discutieron las estrategias de comunicación y educación. “Desde nuestra institución se presentaron las líneas de trabajo actuales destacando el inicio de actividades en conjunto con el centro internacional para solucionar la RAM de Dinamarca (ICARS)”, afirmó Redondo.
Para concluir, el investigador subrayó: “La resistencia a los antimicrobianos es un problema que lejos de solucionarse nos plantea un desafío constante con el que tendremos que aprender a convivir”. En esa línea agregó que “nuestro país a través de los esfuerzos combinados de las diferentes instituciones ha demostrado un gran compromiso en la lucha con este problema, convirtiéndose en un referente de alto nivel en la región”.
FUENTE: INTA